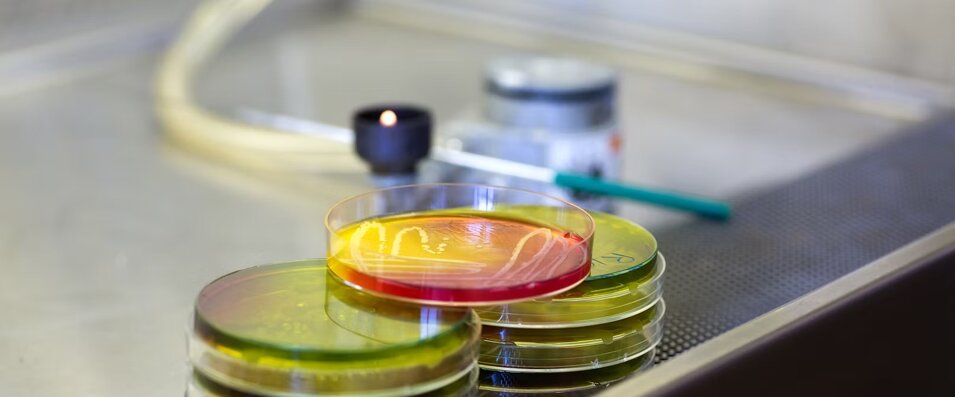

certificazioni
UNI EN ISO 9001:2015
SERVIZI
Consulenza completa su tutti gli aspetti di sicurezza sul lavoro legati al D.Lgs. 81/08: dall’igiene alla tutela ambientale, dalla prevenzione dei rischi alla redazione di tutti i documenti.
Effettuiamo corsi di formazione ed addestramento in materia di sicurezza, con un’attenzione particolare ai metodi formativi e alla costruzione di corsi personalizzati alle esigenze del cliente, in modalità presenziale e webinar.
Offriamo alle aziende che necessitano di sottoporre i propri lavoratori a sorveglianza sanitaria la consulenza dei nostri medici competenti.
Svolgiamo attività di progettazione strutturale ed architettonica, alla direzione lavori e coordinamento della sicurezza in fase di progettazione ed esecuzione dei lavori, al collaudo delle opere.
Effettuiamo corsi di formazione ed addestramento in materia di sicurezza, con un’attenzione particolare ai metodi formativi e alla costruzione di corsi personalizzati alle esigenze del cliente, in modalità presenziale e webinar.
Affianchiamo i nostri clienti nella gestione, nell'individuazione e nel monitoraggio dei punti della lavorazione degli alimenti in cui si prospetta un pericolo di contaminazione biologica, chimica o fisica.
Offriamo ai nostri clienti un team di porfessionisti in grado di progettare e realizzare le attività di cablaggio in fibra ottica di interi comuni
Offriamo ai nostri clienti consulenza e assistenza per l’accesso ed ottenimento delle misure a sostegno delle PMI per mezzo delle agevolazioni del credito di imposta e dell'accesso ai fondi interprofessionali
Offriamo ai nostri clienti la creazione di siti web professionali e personalizzati in funzione delle specifiche esigenze.
Verifichiamo la presenza dei requisiti, raccogliamo e analizziamo la documentazione, e offriamo ai nostri clienti assistenza fino al rilascio dell'attestato da parte dell'Organismo di Attestazione.
Offriamo ai nostri clienti consulenza e assistenza per l'ottenimento della certificazione di conformità secondo la norma ISO di riferimento (es. ISO 9001), attraverso contratti personalizzati, con precisi obiettivi temporali ed economici.
Corsi di formazione destinati al personale che opera nelle imprese qualificate con Enel e/o imprese in fase di qualificazione che fanno riferimento alla Specifica Enel APR 037 edizione corrente / documento requisiti di qualificazione edizione corrente.
CHI SIAMO
La Società MiVa Consulting S.r.l.s. nasce il 1 dicembre 2017 dalla volontà di due fratelli, Emiliano e Fabio Missanelli, di unire i loro differenti percorsi di studi e differenti esperienze lavorative per creare una propria e autonoma realtà aziendale.
La Società svolge attività di consulenza aziendale ad enti pubblici e privati in materia di sicurezza sui luoghi di lavoro e in campo ingegneristico. La sede è sita a via Toma 6 C in Napoli, al centro del Vomero affacciandosi da un lato sulla Villa S. Lucia (Floridiana) e dall’altro sulla splendida vista del Golfo di Napoli.
Obiettivo principale della Società è quello di fornire ai propri clienti un rapporto esclusivo organizzando la consulenza totalmente in funzione delle necessità e richieste del cliente. La totalità della clientela, riscontrando la massima disponibilità e collaborazione della Società, si fidelizza nel corso del tempo.
Dal 2019 collabora con la società ALTEN ITALIA, assicurando risorse nella direzione dei lavori per i cantieri di posa fibra ottica (FTTH) della ditta Open Fiber Spa per il comune di Napoli.
Dal 2022 la Miva Consulting diventa partner della società Fibermind ed Accenture fornendo il servizio delle risorse professionali quali direzione lavori, coordinamento sicurezza e permit per i cantieri di posa fibra ottica (FTTH) della ditta Open Fiber Spa presso i comuni di San Giorgio a Cremano, Portici, Torre del Greco, Caserta e Angri.
Dal 2023 la Miva Consulting offre il servizio delle risorse professionali quali responsabile dei lavori, direzione lavori, coordinamento sicurezza per i cantieri TIM Spa e Fibercop Spa.
Il team della società è composto da ingegneri esperti in progettazione strutturale ed architettonica, esperiti in sicurezza sui luoghi di lavoro in ambito aziendale, cantieristico e medicina del lavoro.
La Società MiVa Consulting S.r.l.s ha una MISSION: SUPPORTARE IMPRESE E TERRITORIO, OFFRENDO SERVIZI E SOLUZIONI PER LA CREAZIONE DI VALORE garantendo la massima professionalità e disponibilità.




ING. STEFANO DEL GAUDIO
ING. GIUSY CASTELLAMMARE
ING. FABIO MISSANELLI
DOTT. EMILIANO MISSANELLI




ING. MARIAFRANCESCA PAROLA
ING. ANTONELLA D'AVINO
DOTT.SSA SARAH CARNEVALE
DOTT.SSA RAFFAELLA COLABELLA


politica per la qualita'
CLIENTI & PARTNER











CONTATTI
CONTATTACI
Sede operativa 1:
Via Gioacchino Toma, 6 C
Napoli
Sede operativa 2:
Via Nazionale delle Puglie 7 - Centro il Faro Casalnuovo di Napoli (NA)
+39 081 18835267
+39 342 810 1587
Lun - Ven 09:00 - 13:00
14:00 - 18:00
Sab - Dom Chiuso


 SICUREZZA SUL LAVORO
SICUREZZA SUL LAVORO AGEVOLAZIONI AZIENDALI E FONDI INTERPROFESSIONALI
AGEVOLAZIONI AZIENDALI E FONDI INTERPROFESSIONALI ATTESTAZIONE SOA
ATTESTAZIONE SOA CERTIFICAZIONE SA 8000
CERTIFICAZIONE SA 8000 SISTEMI DI GESTIONE
SISTEMI DI GESTIONE H.A.C.C.P.
H.A.C.C.P. INGEGNERIA & ARCHITETTURA
INGEGNERIA & ARCHITETTURA CORSI DI FORMAZIONE
CORSI DI FORMAZIONE MEDICINA DEL LAVORO
MEDICINA DEL LAVORO










.jpeg)
